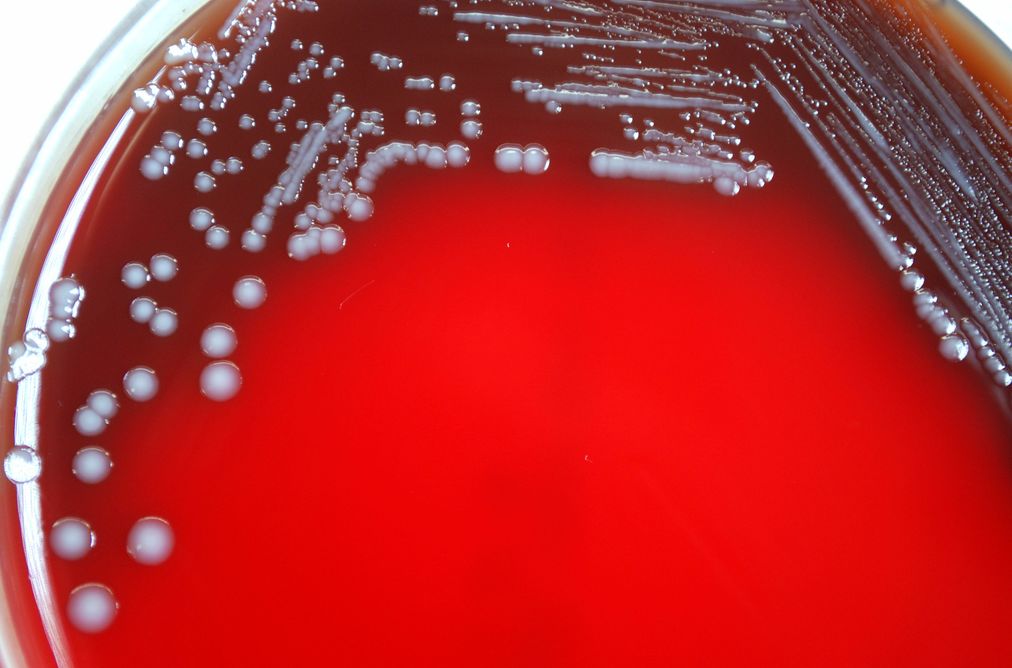

Microelectronics has transformed our lives. Cellphones, earbuds, pacemakers, defibrillators – all these and more rely on microelectronics’ very small electronic designs and components. Microelectronics has changed the way we collect, process and transmit information.
Such devices, however, rarely provide access to our biological world; there are technical gaps. We can’t simply connect our cellphones to our skin and expect to gain health information. For instance, is there an infection? What type of bacteria or virus is involved? We also can’t program the cellphone to make and deliver an antibiotic, even if we knew whether the pathogen was Staph or Strep. There’s a translation problem when you want the world of biology to communicate with the world of electronics.
The research we’ve just published with colleagues in Nature Communications brings us one step closer to closing that communication gap. Rather than relying on the usual molecular signals, like hormones or nutrients, that control a cell’s gene expression, we created a synthetic “switching” system in bacterial cells that recognizes electrons instead. This new technology – a link between electrons and biology – may ultimately allow us to program our phones or other microelectronic devices to autonomously detect and treat disease.
Communicating with electrons, not molecules
One of the barriers scientists have encountered when trying to link microelectronic devices with biological systems has to do with information flow. In biology, almost all activity is made possible by the transfer of molecules like glucose, epinephrine, cholesterol and insulin signaling between cells and tissues. Infecting bacteria secrete molecular toxins and attach to our skin using molecular receptors. To treat an infection, we need to detect these molecules to identify the bacteria, discern their activities and determine how to best respond.
Microelectronic devices don’t process information with molecules. A microelectronic device typically has silicon, gold, chemicals like boron or phosphorus and an energy source that provides electrons. By themselves, they’re poorly suited to engage in molecular communication with living cells.
Free electrons don’t exist in biological systems so there’s almost no way to connect with microelectronics. There is, however, a small class of molecules that stably shuttle electrons. These are called “redox” molecules; they can transport electrons, sort of like wire does. The difference is that in wire, the electrons can flow freely to any location within; redox molecules must undergo chemical reactions – oxidation or reduction reactions – to “hand off” electrons.

Turning cells on and off
Capitalizing on the electronic nature of redox molecules, we genetically engineered bacteria to respond to them. We focused on redox molecules that could be “programmed” by the electrode of a microelectronic device. The device toggles the molecule’s oxidation state – it’s either oxidized (loses an electron) or reduced (gains an electron). The electron is supplied by a typical energy source in electronics like a battery.
We wanted our bacteria cells to turn “on” and “off” due to the applied voltage – voltage that oxidized a naturally occurring redox molecule, pyocyanin.
Electrically oxidizing pyocyanin allowed us to control our engineered cells, turning them on or off so they would synthesize (or not) a fluorescent protein. We could rapidly identify what was happening in these cells because the protein emits a green hue.
In another example, we made bacteria that, when switched on, would swim from a stationary position. Bacteria normally swim in starts and stops referred to as a “run” or a “tumble.” The “run” ensures they move in a straight path. When they “tumble,” they essentially remain in a one spot. A protein called CheZ controls the “run” portion of bacteria’s swimming activity. Our electrogenetic switch turned on the synthesis of CheZ, so that the bacteria could move forward.

We were also able to electrically signal a community of cells to exhibit collective behavior. We made cells with switches controlling the synthesis of a signaling molecule that diffuses to neighboring cells and, in turn, causes changes in their behavior. Electric current turned on cells that, in turn, “programmed” a natural biological signaling process to alter the behavior of nearby cells. We exploited bacterial quorum sensing – a natural process where bacterial cells “talk” to their neighbors and the collection of cells can behave in ways that benefit the entire community.
Perhaps even more interesting, our groups showed that we could both turn on gene expression and turn it off. By reversing the polarity on the electrode, the oxidized pyocyanin becomes reduced – its inactive form. Then, the cells that were turned on were engineered to quickly revert back to their original state. In this way, the group demonstrated the ability to cycle the electrically programmed behavior on and off, repeatedly.
Interestingly, the on and off switch enabled by pyocyanin was fairly weak. By including another redox molecule, ferricyanide, we found a way to amplify the entire system so that the gene expression was very strong, again on and off. The entire system was robust, repeatable and didn’t negatively affect the cells.
Sensing and responding on a cellular level
Armed with this advance, devices could potentially electrically stimulate bacteria to make therapeutics and deliver them to a site. For example, imagine swallowing a small microelectronic capsule that could record the presence of a pathogen in your GI tract and also contain living bacterial factories that could make an antimicrobial or other therapy – all in a programmable autonomous system.
This current research ties into previous work done here at the University of Maryland where researchers had discovered ways to “record” biological information, by sensing the biological environment, and based on the prevailing conditions, “write” electrons to devices. We and our colleagues “sent out” redox molecules from electrodes, let those molecules interact with the microenvironment near the electrode and then drew them back to the electrode so they could inform the device on what they’d seen. This mode of “molecular communication” is somewhat analogous to sonar, where redox molecules are used instead of sound waves.
These molecular communication efforts were used to identify pathogens, monitor the “stress” in blood levels of individuals with schizophrenia and even determine the differences in melanin from people with red hair. For nearly a decade, the Maryland team has developed methodologies to exploit redox molecules to interrogate biology by directly writing the information to devices with electrochemistry.
Perhaps it is now time to integrate these technologies: Use molecular communication to sense biological function and transfer the information to a device. Then use the device – maybe a small capsule or perhaps even a cellphone – to program bacteria to make chemicals and other compounds that issue new directions to the biological system. It may sound fantastical, many years away from practical uses, but our team is working hard on such valuable applications…stay tuned!

Comments on this article are now closed.
Have your say, post a comment on this article.